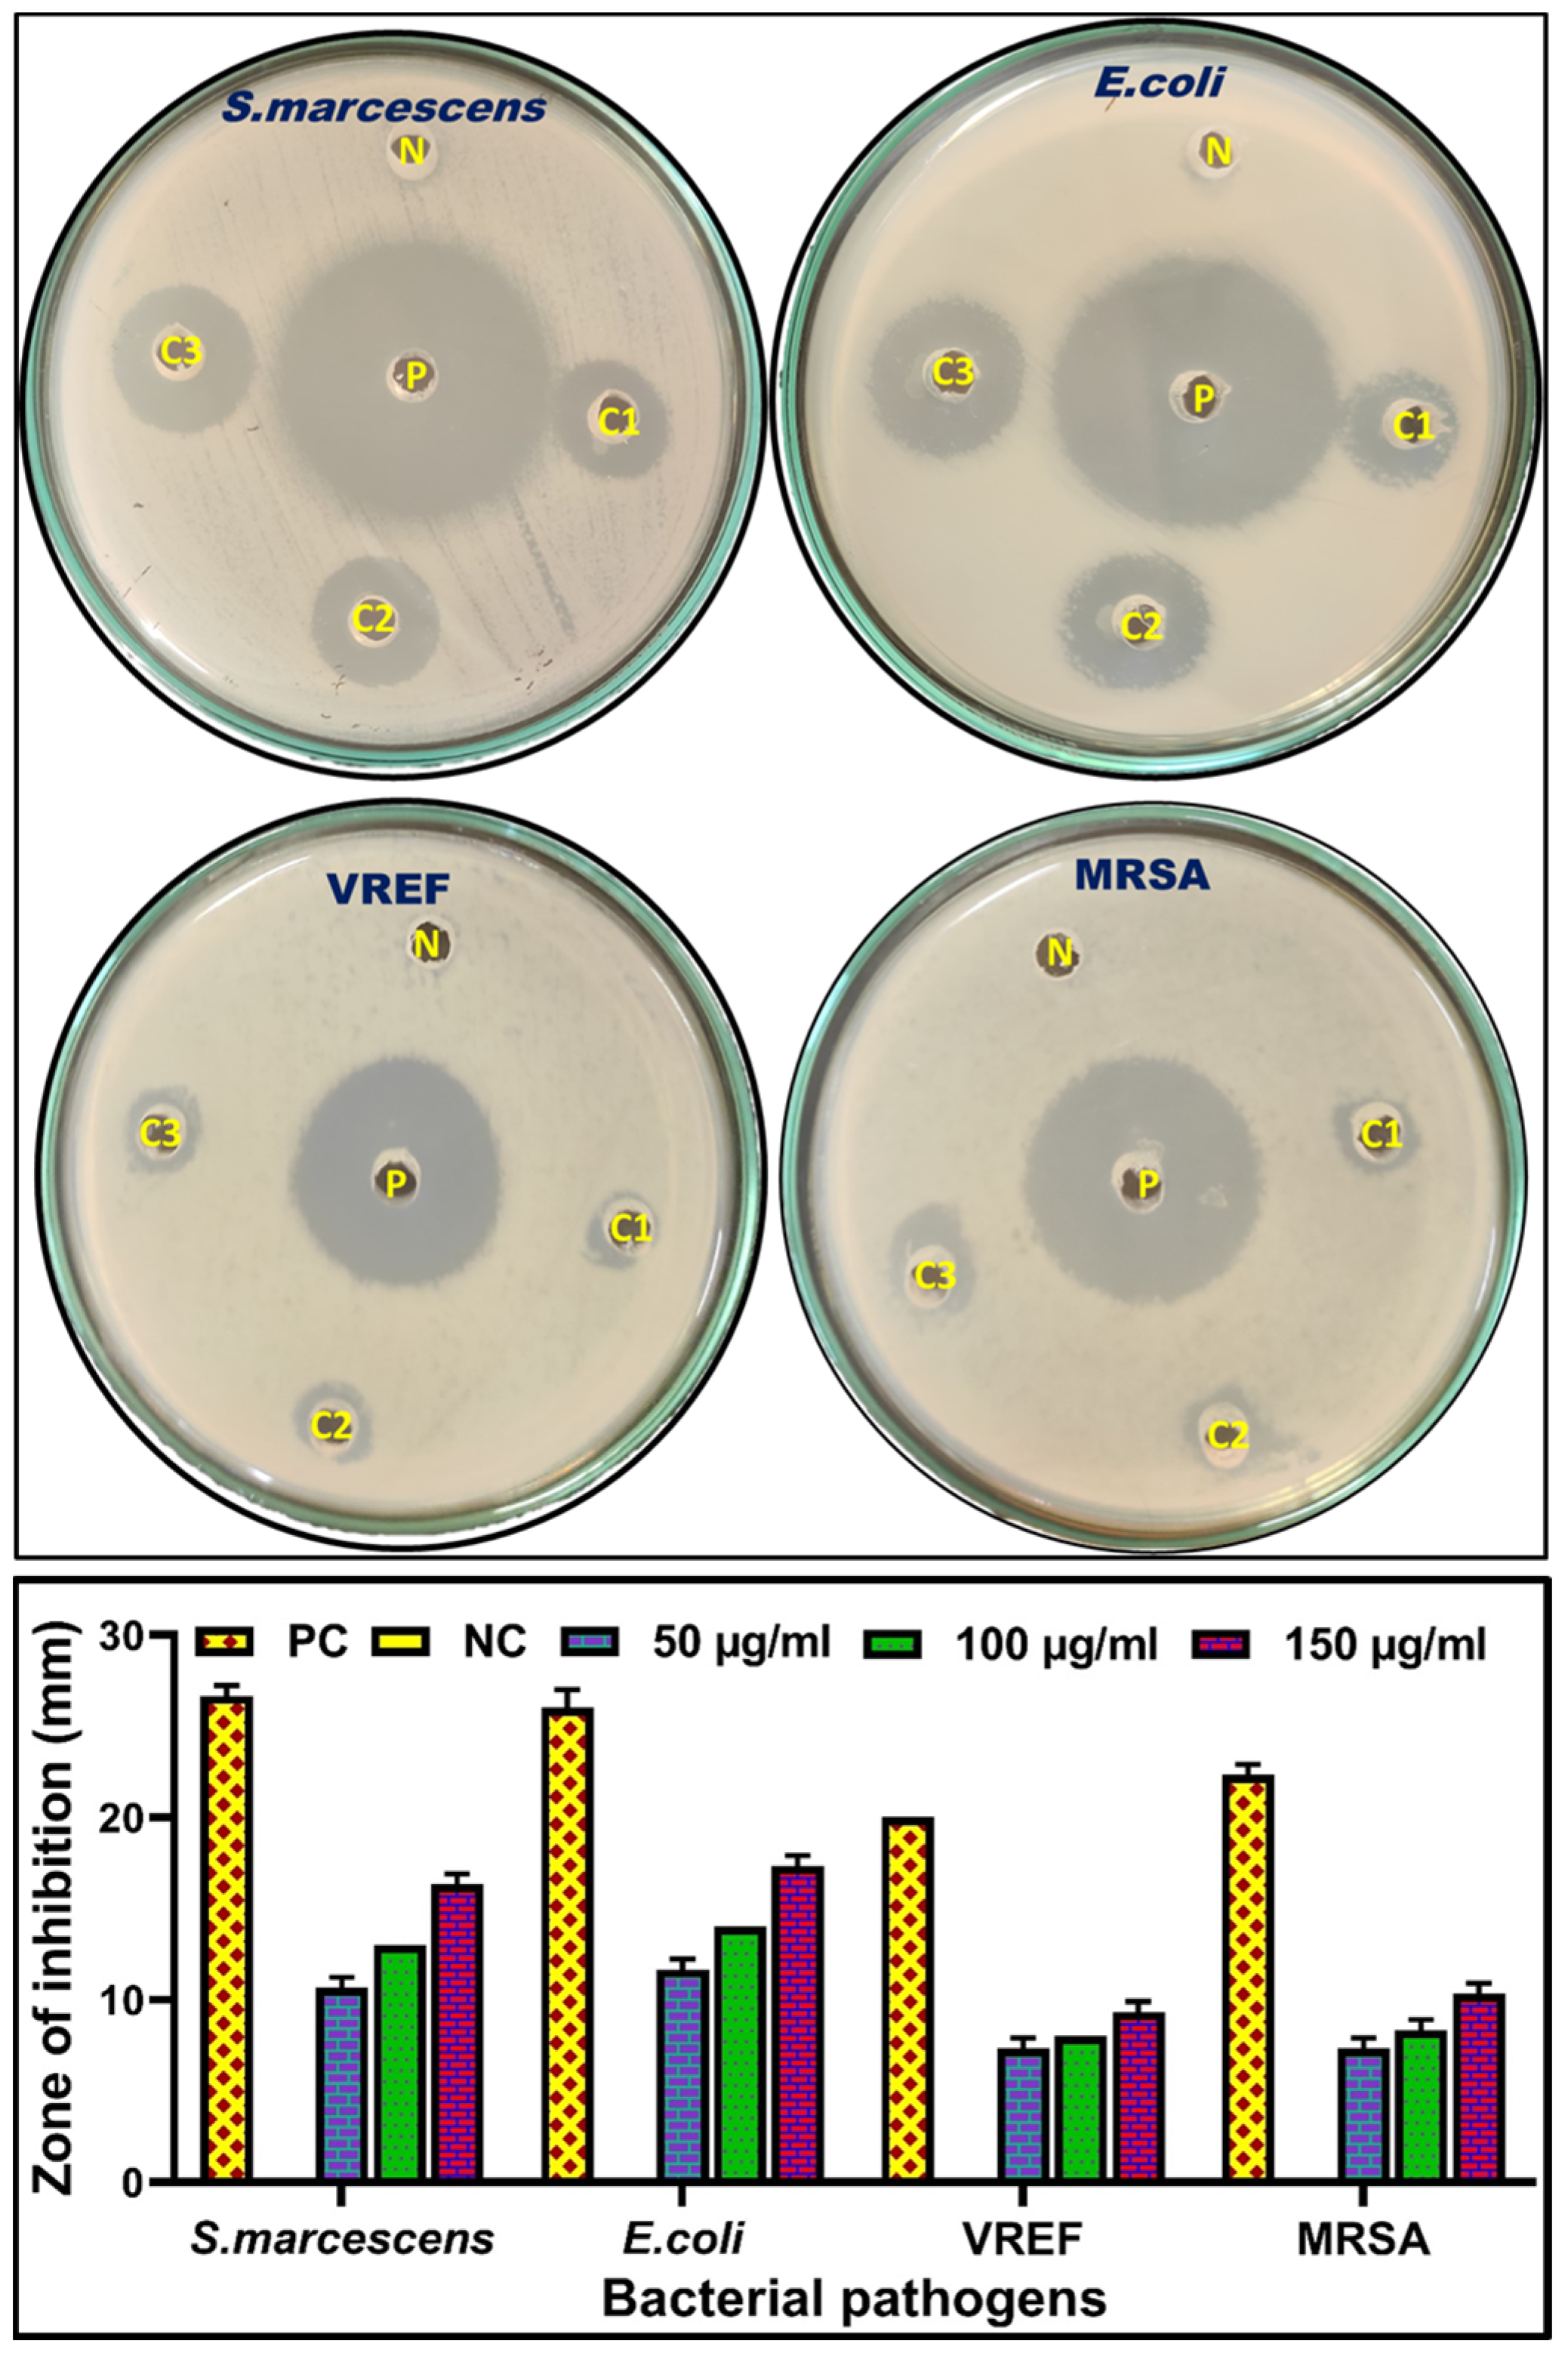

Phyto-Mediated Green Synthesis of Silver Nanoparticles Using an Aqueous Leaf Extract of Momordica cymbalaria: Antioxidant, Cytotoxic, Antibacterial, and Photocatalytic Properties
Abstract
1. Introduction
2. Materials and Methods
2.1. Preparation of Plant Extract
2.2. Phytochemical Analysis
2.3. Gas Chromatography-Mass Spectrometry (GC-MS) Analysis
2.4. Synthesis of AgNPs from M. cymbalaria
2.5. Characterization of Mc-AgNPs
2.5.1. UV-Vis Spectroscopy
2.5.2. Fourier-Transform Infrared Spectroscopy (FT-IR) Analysis
2.5.3. X-ray Diffraction (XRD) Analysis
2.5.4. SEM and EDX Analysis
2.5.5. HR-TEM and SAED Analysis
2.6. DPPH-Radical-Scavenging Assay
2.7. Cytotoxicity Assay
2.8. Antibacterial Activity
Microbial Growth Assay
2.9. Photocatalytic Activity
2.10. Statistical Analysis
3. Results and Discussion
3.1. GC-MS Analysis
3.2. Green Synthesis of Mc-AgNPs
3.3. Characterization of Mc-AgNPs
3.3.1. UV-Vis Spectroscopic Analysis
3.3.2. FT-IR Analysis
3.3.3. XRD Analysis
3.3.4. SEM and E.D.X. Analysis
3.3.5. HR-TEM with SAED Analysis
3.4. DPPH Assay
3.5. Cytotoxicity Activity
3.6. Antibacterial Activity
Microbial Growth Assay
3.7. Photocatalytic Studies
Reusability Test and Stability Analysis of Mc-AgNPs
4. Conclusions
Author Contributions
Funding
Data Availability Statement
Conflicts of Interest
References
- He, X.; Deng, H.; Hwang, H.M. The current application of nanotechnology in food and agriculture. J. Food Drug Anal. 2019, 27, 1–21. [Google Scholar] [CrossRef] [PubMed]
- Mariappan, V.; Vellasamy, K.M.; Mohamad, N.A.; Subramaniam, S.; Vadivelu, J. OneHealth approaches contribute towards antimicrobial resistance: Malaysian perspective. Front. Microbiol. 2021, 12, 718774. [Google Scholar] [CrossRef] [PubMed]
- Shankar, P.R. Book review: Tackling drug-resistant infections globally. Arch. Pharm. Pract. 2016, 7, 110–111. [Google Scholar] [CrossRef]
- Sánchez-López, E.; Gomes, D.; Esteruelas, G.; Bonilla, L.; Lopez-Machado, A.L.; Galindo, R.; Cano, A.; Espina, M.; Ettcheto, M.; Camins, A.; et al. Metal-based nanoparticles as antimicrobial agents: An overview. Nanomaterials 2020, 10, 292. [Google Scholar] [CrossRef] [PubMed]
- Ferlay, J.; Colombet, M.; Soerjomataram, I.; Mathers, C.; Parkin, D.M.; Piñeros, M.; Znaor, A.; Bray, F. Estimating the global cancer incidence and mortality in 2018: GLOBOCAN sources and methods. Int. J. Cancer 2019, 144, 1941–1953. [Google Scholar] [CrossRef] [PubMed]
- Curigliano, G.; Criscitiello, C. Successes and limitations of targeted cancer therapy in breast cancer. Successes Limit. Target. Cancer Ther. 2014, 41, 15–35. [Google Scholar]
- Kumari, P.; Ghosh, B.; Biswas, S. Nanocarriers for cancer-targeted drug delivery. J. Drug Target. 2016, 24, 179–191. [Google Scholar] [CrossRef]
- Tang, X.; Cai, S.; Zhang, R.; Liu, P.; Chen, H.; Zheng, Y.; Sun, L. Paclitaxel-loaded nanoparticles of star-shaped cholic acid-core PLA-TPGS copolymer for breast cancer treatment. Nanoscale Res. Lett. 2013, 8, 420. [Google Scholar] [CrossRef]
- Abdalla, A.M.; Xiao, L.; Ullah, M.W.; Yu, M.; Ouyang, C.; Yang, G. Current challenges of cancer anti-angiogenic therapy and the promise of nanotherapeutics. Theranostics 2018, 8, 533. [Google Scholar] [CrossRef] [PubMed]
- Khan, A.U.; Yuan, Q.; Khan, Z.U.H.; Ahmad, A.; Khan, F.U.; Tahir, K.; Shakeel, M.; Ullah, S. An eco-benign synthesis of AgNPs using aqueous extract of Longan fruit peel: Antiproliferative response against human breast cancer cell line MCF-7, antioxidant and photocatalytic deprivation of methylene blue. J. Photochem. Photobiol. B Biol. 2018, 183, 367–373. [Google Scholar] [CrossRef] [PubMed]
- Alsukaibi, A.K. Various approaches for the detoxification of toxic dyes in wastewater. Processes 2022, 10, 1968. [Google Scholar] [CrossRef]
- Khan, A.U.; Yuan, Q.; Wei, Y.; Tahir, K.; Khan, S.U.; Ahmad, A.; Khan, S.; Nazir, S.; Khan, F.U. Ultra-efficient photocatalytic deprivation of methylene blue and biological activities of biogenic silver nanoparticles. J. Photochem. Photobiol. B Biol. 2016, 159, 49–58. [Google Scholar] [CrossRef]
- Narayan, N.; Meiyazhagan, A.; Vajtai, R. Metal nanoparticles as green catalysts. Materials 2019, 12, 3602. [Google Scholar] [CrossRef]
- Tanase, C.; Berta, L.; Coman, N.A.; Roșca, I.; Man, A.; Toma, F.; Mocan, A.; Jakab-Farkas, L.; Biró, D.; Mare, A. Investigation of in vitro antioxidant and antibacterial potential of silver nanoparticles obtained by biosynthesis using beech bark extract. Antioxidants 2019, 8, 459. [Google Scholar] [CrossRef]
- Behboodi, S.; Baghbani-Arani, F.; Abdalan, S.; Sadat Shandiz, S.A. Green engineered biomolecule-capped silver nanoparticles fabricated from Cichorium intybus extract: In vitro assessment on apoptosis properties toward human breast cancer (MCF-7) cells. Biol. Trace Elem. Res. 2019, 187, 392–402. [Google Scholar] [CrossRef] [PubMed]
- Alqudami, A.; Annapoorni, S. Fluorescence from metallic silver and iron nanoparticles prepared by exploding wire technique. Plasmonics 2007, 2, 5–13. [Google Scholar] [CrossRef]
- Jyoti, K.; Baunthiyal, M.; Singh, A. Characterization of silver nanoparticles synthesized using Urtica dioica Linn. leaves and their synergistic effects with antibiotics. J. Radiat. Res. Appl. Sci. 2016, 9, 217–227. [Google Scholar] [CrossRef]
- Sharma, N.K.; Vishwakarma, J.; Rai, S.; Alomar, T.S.; AlMasoud, N.; Bhattarai, A. Green route synthesis and characterization techniques of silver nanoparticles and their biological adeptness. ACS Omega 2022, 7, 27004–27020. [Google Scholar] [CrossRef] [PubMed]
- Gengan, R.M.; Anand, K.; Phulukdaree, A.; Chuturgoon, A. A549 lung cell line activity of biosynthesized silver nanoparticles using Albizia adianthifolia leaf. Colloids Surf. B Biointerfaces 2013, 105, 87–91. [Google Scholar] [CrossRef] [PubMed]
- Kumar, D.; Kumar, P.; Singh, H.; Agrawal, V. Biocontrol of mosquito vectors through herbal-derived silver nanoparticles: Prospects and challenges. Environ. Sci. Pollut. Res. 2020, 27, 25987–26024. [Google Scholar] [CrossRef] [PubMed]
- Adeyemi, J.O.; Oriola, A.O.; Onwudiwe, D.C.; Oyedeji, A.O. Plant extracts mediated metal-based nanoparticles: Synthesis and biological applications. Biomolecules 2022, 12, 627. [Google Scholar] [CrossRef]
- Rajan, R.; Chandran, K.; Harper, S.L.; Yun, S.I.; Kalaichelvan, P.T. Plant extract synthesized silver nanoparticles: An ongoing source of novel biocompatible materials. Ind. Crops Prod. 2015, 70, 356–373. [Google Scholar] [CrossRef]
- Jeyadevi, R.A.; Sivasudha, T.; Rameshkumar, A.; Sangeetha, B.; Ananth, D.A.; Aseervatham, G.S.B. Nutritional constituents and medicinal values of Momordica cymbalaria (Athalakkai)–A review. Asian Pac. J. Trop. Biomed. 2012, 2, S456–S461. [Google Scholar] [CrossRef]
- Gopu, C.; Chirumamilla, P.; Kagithoju, S.; Taduri, S. Green synthesis of silver nanoparticles using Momordica cymbalaria aqueous leaf extracts and screening of their antimicrobial activity: AgNPs studies in Momordica cymba-laria. Proc. Natl. Acad. Sci. India Sect. B Biol. Sci. 2022, 92, 771–782. [Google Scholar] [CrossRef]
- Sundar, M.; Suresh, S.; Lingakumar, K. Influence of Caralluma adscendens Var. attenuata cold cream on UV-B damaged skin epidermal cells: A novel approach. 3 Biotech 2021, 11, 155. [Google Scholar] [CrossRef]
- Anand, T.; Sundararajan, M.; Anbukkarasi, M.; Thomas, P.A.; Geraldine, P.A. methanolic extract of Ocimum basilicum exhibits antioxidant effects and prevents selenite-induced cataract formation in cultured lenses of Wistar rats. Pharmacogn. J. 2019, 11, 496–504. [Google Scholar] [CrossRef]
- Swamy, M.K.; Akhtar, M.S.; Mohanty, S.K.; Sinniah, U.R. Synthesis and characterization of silver nanoparticles using fruit extract of Momordica cymbalaria and assessment of their in vitro antimicrobial, antioxidant and cytotoxicity activities. Spectrochim. Acta A Mol. Biomol. Spectrosc. 2015, 151, 939–944. [Google Scholar] [CrossRef] [PubMed]
- Jha, D.K.; Koneri, R.; Samaddar, S. Potential bio-resources of Momordica dioica roxb: A review. Int. J. Pharm. Sci. Rev. Res. 2017, 45, 203–209. [Google Scholar]
- Kumar, A.; Dubey, A.; Singh, R. Investigation on Anti-Ulcer Activity of Momordica dioica Fruits in Wistar Rat. Int. J. Res. Appl. Sci. Biotechnol. 2022, 9, 105–111. [Google Scholar] [CrossRef]
- Choudhary, B.R.; Berwal, M.K.; Ram, H.; Choudhary, M.K.; Singh, D. Momordica balsamina L.: An unexploited vegetable crop rich in medicinal and nutritional properties. J. Agric. Ecol. 2022, 14, 84–92. [Google Scholar] [CrossRef]
- Elangovan, A.; Subramanian, A.; Durairaj, S.; Ramachandran, J.; Lakshmanan, D.K.; Ravichandran, G.; Nambirajan, G.; Thilagar, S. Antidiabetic and hypolipidemic efficacy of skin and seed extracts of Momordica cymbalaria on alloxan induced diabetic model in rats. J. Ethnopharmacol. 2019, 241, 111989. [Google Scholar] [CrossRef]
- Ramesh, M.; Rao, Y.N.; Rao, A.A.; Prabhakar, M.C.; Rao, C.S.; Muralidhar, N.; Reddy, B.M. Antinociceptive and anti-inflammatory activity of a flavonoid isolated from Caralluma attenuata. J. Ethnopharmacol. 1998, 62, 63–66. [Google Scholar] [CrossRef]
- Jia, R.B.; Wu, J.; Li, Z.R.; Ou, Z.R.; Lin, L.; Sun, B.; Zhao, M. Structural characterization of polysaccharides from three seaweed species and their hypoglycemic and hypolipidemic activities in type 2 diabetic rats. Int. J. Biol. Macromol. 2020, 155, 1040–1049. [Google Scholar] [CrossRef]
- Jain, A.; Soni, M.; Deb, L.; Jain, A.; Rout, S.P.; Gupta, V.B.; Krishna, K.L. Antioxidant and hepatoprotective activity of ethanolic and aqueous extracts of Momordica dioica Roxb. leaves. J. Ethnopharmacol. 2008, 115, 61–66. [Google Scholar] [CrossRef]
- Jha, D.K.; Koneri, R.; Samaddar, S. Medicinal use of an ancient herb Momordica cymbalaria: A review. Int. J. Pharm. Sci. Res. 2018, 9, 432–441. [Google Scholar]
- Ahn, E.Y.; Jin, H.; Park, Y. Assessing the antioxidant, cytotoxic, apoptotic and wound healing properties of silver nanoparticles green-synthesized by plant extracts. Mater. Sci. Eng. C 2019, 101, 204–216. [Google Scholar] [CrossRef] [PubMed]
- Fahimirad, S.; Ajalloueian, F.; Ghorbanpour, M. Synthesis and therapeutic potential of silver nanomaterials derived from plant extracts. Ecotoxicol. Environ. Saf. 2019, 168, 260–278. [Google Scholar] [CrossRef] [PubMed]
- Haggag, E.G.; Elshamy, A.M.; Rabeh, M.A.; Gabr, N.M.; Salem, M.; Youssif, K.A.; Samir, A.; Bin Muhsinah, A.; Alsayari, A.; Abdelmohsen, U.R. Antiviral potential of green synthesized silver nanoparticles of Lampranthus coccineus and Malephora lutea. Int. J. Nanomed. 2019, 14, 6217–6229. [Google Scholar] [CrossRef] [PubMed]
- Totaro, P.; Rambaldini, M. Efficacy of antimicrobial activity of slow release silver nanoparticles dressing in post-cardiac surgery mediastinitis. Interact. Cardiovasc. Thorac. Surg. 2009, 8, 153–154. [Google Scholar] [CrossRef] [PubMed]
- Bobo, D.; Robinson, K.J.; Islam, J.; Thurecht, K.J.; Corrie, S.R. Nanoparticle-based medicines: A review of FDA-approved materials and clinical trials to date. Pharm. Res. 2016, 33, 2373–2387. [Google Scholar] [CrossRef]
- Buniyamin, I.; Akhir, R.M.; Asli, N.A.; Khusaimi, Z.; Malek, M.F.; Mahmood, M.R. Nanotechnology applications in biomedical systems. Curr. Nanomater. 2022, 7, 167–180. [Google Scholar] [CrossRef]
- Waghchaure, R.H.; Adole, V.A. Biosynthesis of metal and metal oxide nanoparticles using various parts of plants for antibacterial, antifungal and anticancer activity: A review. J. Indian Chem. Soc. 2023, 100, 100987. [Google Scholar] [CrossRef]
- Chandrasekharan, S.; Chinnasamy, G.; Bhatnagar, S. Sustainable phyto-fabrication of silver nanoparticles using Gmelina arborea exhibit antimicrobial and biofilm inhibition activity. Sci. Rep. 2022, 12, 156. [Google Scholar] [CrossRef] [PubMed]
- Shreyash, N.; Bajpai, S.; Khan, M.A.; Vijay, Y.; Tiwary, S.K.; Sonker, M. Green synthesis of nanoparticles and their biomedical applications: A review. ACS Appl. Nano Mater. 2021, 4, 11428–11457. [Google Scholar] [CrossRef]
- Jabeen, S.; Qureshi, R.; Munazir, M.; Maqsood, M.; Munir, M.; Shah, S.S.H.; Rahim, B.Z. Application of green synthesized silver nanoparticles in cancer treatment—A critical review. Mater. Res. Express 2021, 8, 092001. [Google Scholar] [CrossRef]
- Sanpui, P.; Chattopadhyay, A.; Ghosh, S.S. Induction of apoptosis in cancer cells at low silver nanoparticle concentrations using chitosan nanocarrier. ACS Appl. Mater. Interfaces 2011, 3, 218–228. [Google Scholar] [CrossRef] [PubMed]
- Kumar, H.; Bhardwaj, K.; Nepovimova, E.; Kuča, K.; Singh Dhanjal, D.; Bhardwaj, S.; Bhatia, S.K.; Verma, R.; Kumar, D. Antioxidant functionalized nanoparticles: A combat against oxidative stress. Nanomaterials 2020, 10, 1334. [Google Scholar] [CrossRef] [PubMed]
- Kashyap, B.K.; Singh, V.V.; Solanki, M.K.; Kumar, A.; Ruokolainen, J.; Kesari, K.K. Smart Nanomaterials in Cancer Theranostics: Challenges and Opportunities. ACS Omega 2023, 8, 14290–14320. [Google Scholar] [CrossRef] [PubMed]
- Saravanan, H.; Subramani, T.; Rajaramon, S.; David, H.; Sajeevan, A.; Sujith, S.; Solomon, A.P. Exploring nanocomposites for controlling infectious microorganisms: Charting the path forward in antimicrobial strategies. Front. Pharmacol. 2023, 14, 1282073. [Google Scholar] [CrossRef] [PubMed]
- Zykova, M.V.; Volikov, A.B.; Buyko, E.E.; Bratishko, K.A.; Ivanov, V.V.; Konstantinov, A.I.; Logvinova, L.A.; Mihalyov, D.A.; Sobolev, N.A.; Zhirkova, A.M.; et al. Enhanced Antioxidant Activity and Reduced Cytotoxicity of Silver Nanoparticles Stabilized by Different Humic Materials. Polymers 2023, 15, 3386. [Google Scholar] [CrossRef]
- Wagner, H. Pharmazeutische Biology AUFI; Gustav Fisher Verlag: Stuttgart, Germany, 1993; p. 184, 15 BN 3-437-20 498-X. [Google Scholar]
- Harborne, J.B.; Williams, C.A. Anthocyanins and other flavonoids. Nat. Prod. Rep. 1998, 15, 631–652. [Google Scholar] [CrossRef]
- Little, E.; Ramakrishnan, M.; Roy, B.; Gazit, G.; Lee, A.S. The glucose-regulated proteins (GRP78 and GRP94): Functions, gene regulation, and applications. Crit. Rev. Eukaryot. Gene Expr. 1994, 4, 1–18. [Google Scholar] [CrossRef]
- Raaman, N. Phytochemical Techniques; New India Publishing: Pitampura, India, 2006. [Google Scholar]
- Kokate, C.K.; Purohit, A.P.; Gokhale, S.B. Pharmacognosy, Nirali Prakashan, Pune. Med. J. 2002, 43, 77–85. [Google Scholar]
- Edeoga, H.O.; Okwu, D.E.; Mbaebie, B.O. Phytochemical constituents of some Nigerian medicinal plants. Afr. J. Biotechnol. 2005, 4, 685–688. [Google Scholar] [CrossRef]
- Rajagopal, G.; Manivannan, N.; Sundararajan, M.; Kumar, A.G.; Senthilkumar, S.; Mathivanan, N.; Ilango, S. Biocompatibility assessment of silver chloride nanoparticles derived from Padina gymnospora and its therapeutic potential. Nano Express 2021, 2, 010010. [Google Scholar] [CrossRef]
- Anand, T.; Anbukkarasi, M.; Thomas, P.A.; Geraldine, P.A. Comparison between plain eugenol and eugenol-loaded chitosan nanoparticles for prevention of in vitro selenite-induced cataractogenesis. J. Drug Deliv. Sci. Technol. 2021, 65, 102696. [Google Scholar] [CrossRef]
- Rajagopal, G.; Nivetha, A.; Sundar, M.; Panneerselvam, T.; Murugesan, S.; Parasuraman, P.; Kumar, S.; Ilango, S.; Kunjiappan, S. Mixed phytochemicals mediated synthesis of copper nanoparticles for anticancer and larvicidal applications. Heliyon 2021, 7, e07360. [Google Scholar] [CrossRef]
- Mosmann, T. Rapid colorimetric assay for cellular growth and survival: Application to proliferation and cytotoxicity assays. J. Immunol. Methods 1998, 65, 55–63. [Google Scholar] [CrossRef] [PubMed]
- Rajagopal, G.; Nivetha, A.; Ilango, S.; Muthudevi, G.P.; Prabha, I.; Arthimanju, R. Phytofabrication of selenium nanoparticles using Azolla pinnata: Evaluation of catalytic properties in oxidation, antioxidant and antimicrobial activities. J. Environ. Chem. Eng. 2021, 9, 105483. [Google Scholar] [CrossRef]
- Kasithevar, M.; Saravanan, M.; Prakash, P.; Kumar, H.; Ovais, M.; Barabadi, H.; Shinwari, Z.K. Green synthesis of silver nanoparticles using Alysicarpus monilifer leaf extract and its antibacterial activity against MRSA and CoNS isolates in HIV patients. J. Interdiscip. Nanomed. 2017, 2, 131–141. [Google Scholar] [CrossRef]
- Nivetha, A.; Prabha, I. Surfactant-Enhanced Nano Spinel Oxide for Applications in Catalysis, Dye Degradation and Antibacterial Activity. ChemistrySelect 2022, 7, e202202389. [Google Scholar] [CrossRef]
- Dilika, F.; Bremner, P.D.; Meyer, J.J.M. Antibacterial activity of linoleic and oleic acids isolated from Helichrysum pedunculatum: A plant used during circumcision rites. Fitoterapia 2000, 71, 450–452. [Google Scholar] [CrossRef]
- Abubacker, M.N.; Devi, P.K. In vitro antifungal potentials of bioactive compound oleic acid, 3-(octadecyloxy) propyl ester isolated from Lepidagathis cristata Willd. (Acanthaceae) inflorescence. Asian Pac. J. Trop. Med. 2014, 7, S190–S193. [Google Scholar] [CrossRef] [PubMed]
- Habeeb Rahuman, H.B.; Dhandapani, R.; Narayanan, S.; Palanivel, V.; Paramasivam, R.; Subbarayalu, R.; Thangavelu, S.; Muthupandian, S. Medicinal plants mediated the green synthesis of silver nanoparticles and their biomedical applications. IET Nanobiotechnol. 2022, 16, 115–144. [Google Scholar] [CrossRef]
- De Carvalho, C.C.; Caramujo, M.J. The various roles of fatty acids. Molecules 2018, 23, 2583. [Google Scholar] [CrossRef] [PubMed]
- Sundar, M.; Lingakumar, K. Investigating the efficacy of topical application of Ipomoea carnea herbal cream in preventing skin damage induced by UVB radiation in a rat model. Heliyon 2023, 9, e19161. [Google Scholar] [CrossRef]
- Zhang, L.; Zhang, W.; Zhang, F.; Jiang, J. Xylo-oligosaccharides and lignin production from Camellia oleifera shell by malic acid hydrolysis at mild conditions. Bioresour. Technol. 2021, 341, 125897. [Google Scholar] [CrossRef] [PubMed]
- Mukherjee, P.K.; Singha, S.; Kar, A.; Chanda, J.; Banerjee, S.; Dasgupta, B.; Haldar, P.K.; Sharma, N. Therapeutic importance of Cucurbitaceae: A medicinally important family. J. Ethnopharmacol. 2022, 282, 114599. [Google Scholar] [CrossRef]
- Mikhailova, E.O. Silver nanoparticles: Mechanism of action and probable bio-application. J. Funct. Biomater. 2020, 11, 84. [Google Scholar] [CrossRef]
- Ansari, M.; Ahmed, S.; Abbasi, A.; Khan, M.T.; Subhan, M.; Bukhari, N.A.; Hatamleh, A.A.; Abdelsalam, N.R. Plant mediated fabrication of silver nanoparticles, process optimization, and impact on tomato plant. Sci. Rep. 2023, 13, 18048. [Google Scholar] [CrossRef]
- Radzikowska-Büchner, E.; Flieger, W.; Pasieczna-Patkowska, S.; Franus, W.; Panek, R.; Korona-Głowniak, I.; Suśniak, K.; Rajtar, B.; Świątek, Ł.; Żuk, N.; et al. Antimicrobial and Apoptotic Efficacy of Plant-Mediated Silver Nanoparticles. Molecules 2023, 28, 5519. [Google Scholar] [CrossRef] [PubMed]
- Bilal, M.; Rasheed, T.; Iqbal, H.M.; Li, C.; Hu, H.; Zhang, X. Development of silver nanoparticles loaded chi-tosan-alginate constructs with biomedical potentialities. Int. J. Biol. Macromol. 2017, 105, 393–400. [Google Scholar] [CrossRef] [PubMed]
- Ahmed, S.; Ahmad, M.; Swami, B.L.; Ikram, S. Green synthesis of silver nanoparticles using Azadirachta indica aqueous leaf extract. J. Radiat. Res. Appl. Sci. 2016, 9, 1–7. [Google Scholar] [CrossRef]
- Dipankar, C.; Murugan, S. The green synthesis, characterization and evaluation of the biological activities of silver nanoparticles synthesized from Iresine herbstii leaf aqueous extracts. Colloids Surf. B Biointerfaces 2012, 98, 112–119. [Google Scholar] [CrossRef] [PubMed]
- Rajkuberan, C.; Prabukumar, S.; Sathishkumar, G.; Wilson, A.; Ravindran, K.; Sivaramakrishnan, S. Facile synthesis of silver nanoparticles using Euphorbia antiquorum L. latex extract and evaluation of their biomedical perspectives as anticancer agents. J. Saudi Chem. Soc. 2017, 21, 911–919. [Google Scholar] [CrossRef]
- Veera, S.; Chirumamilla, P.; Dharavath, S.B.; Maduru, N.; Taduri, S. Facile green synthesis of silver nanoparticles using Corallocarpus epigaeus leaf extract: Structural, photoluminescence and antibacterial properties. Chem. Data Collect. 2023, 45, 101032. [Google Scholar] [CrossRef]
- Jeeva, K.; Thiyagarajan, M.; Elangovan, V.; Geetha, N.; Venkatachalam, P. Caesalpinia coriaria leaf extracts mediated biosynthesis of metallic silver nanoparticles and their antibacterial activity against clinically isolated pathogens. Ind. Crops Prod. 2014, 52, 714–720. [Google Scholar] [CrossRef]
- Sigamoney, M.; Shaik, S.; Govender, P.; Krishna, S.B.N. African leafy vegetables as bio-factories for silver nano-particles: A case study on Amaranthus dubius C Mart. Ex Thell. S. Afr. J. Bot. 2016, 103, 230–240. [Google Scholar] [CrossRef]
- Jagtap, U.B.; Bapat, V.A. Green synthesis of silver nanoparticles using Artocarpus heterophyllus Lam. seed extract and its antibacterial activity. Ind. Crops Prod. 2013, 46, 132–137. [Google Scholar] [CrossRef]
- Khan, M.J.; Shameli, K.; Sazili, A.Q.; Selamat, J.; Kumari, S. Rapid green synthesis and characterization of silver nanoparticles arbitrated by curcumin in an alkaline medium. Molecules 2019, 24, 719. [Google Scholar] [CrossRef]
- Moond, M.; Singh, S.; Sangwan, S.; Devi, P.; Beniwal, A.; Rani, J.; Kumari, A.; Rani, S. Biosynthesis of silver nano-particles utilizing leaf extract of Trigonella foenum-graecum L. for catalytic dyes degradation and colorimetric sensing of Fe3+/Hg2+. Molecules 2023, 28, 951. [Google Scholar] [CrossRef] [PubMed]
- Khuda, F.; Jamil, M.; Khalil, A.A.K.; Ullah, R.; Ullah, N.; Naureen, F.; Abbas, M.; Khan, M.S.; Ali, S.; Farooqi, H.M.U.; et al. Assessment of antioxidant and cytotoxic potential of silver nanoparticles synthesized from root extract of Reynoutria japonica Houtt. Arab. J. Chem. 2022, 15, 104327. [Google Scholar] [CrossRef]
- Ajaykumar, A.P.; Sabira, O.; Binitha, V.S.; Varma, S.R.; Mathew, A.; Jayaraj, K.N.; Janish, P.A.; Zeena, K.V.; Sheena, P.; Venugopal, V.; et al. Bio-Fabricated Silver Nanoparticles from the Leaf Extract of the Poisonous Plant, Holigarna arnottiana: Assessment of Antimicrobial, Antimitotic, Anticancer, and Radical-Scavenging Properties. Pharmaceutics 2023, 15, 2468. [Google Scholar] [CrossRef] [PubMed]
- Hamida, R.S.; Ali, M.A.; Alfassam, H.E.; Momenah, M.A.; Alkhateeb, M.A.; Bin-Meferij, M.M. One-Step Phytofabrication Method of Silver and Gold Nanoparticles Using Haloxylon Salicornicum for Anticancer, Antimicrobial, and Antioxidant Activities. Pharmaceutics 2023, 15, 529. [Google Scholar] [CrossRef] [PubMed]
- Rasheed, T.; Bilal, M.; Iqbal, H.M.; Li, C. Green biosynthesis of silver nanoparticles using leaves extract of Artemisia vulgaris and their potential biomedical applications. Colloids Surf. B Biointerfaces 2017, 158, 408–415. [Google Scholar] [CrossRef] [PubMed]
- Bordoni, V.; Sanna, L.; Lyu, W.; Avitabile, E.; Zoroddu, S.; Medici, S.; Kelvin, D.J.; Bagella, L. Silver nanoparticles derived by artemisia arborescens reveal anticancer and apoptosis-inducing effects. Int. J. Mol. Sci. 2021, 22, 8621. [Google Scholar] [CrossRef] [PubMed]
- Mariadoss, A.V.A.; Ramachandran, V.; Shalini, V.; Agilan, B.; Franklin, J.H.; Sanjay, K.; Alaa, Y.G.; Tawfiq, M.A.A.; Ernest, D. Green synthesis, characterization and antibacterial activity of silver nanoparticles by Malus domestica and its cytotoxic effect on (MCF-7) cell line. Microb. Pathog. 2019, 135, 103609. [Google Scholar] [CrossRef]
- Ingale, S.; Gaykar, B.; Pagar, K.; Shelke, D. Green Synthesis of Silver Nanoparticles from Cyathocline purpurea (Don) O. Kuntze and Its Efficacy Against MCF-7 Cancer Cell Line. BioNanoScience 2023, 13, 1197–1212. [Google Scholar] [CrossRef]
- Halder, J.; Pradhan, D.; Kar, B.; Ghosh, G.; Rath, G. Nano therapeutics approaches to overcome P-glycoprotein-mediated multi-drug resistance in cancer. Nanomed. NBM 2022, 40, 102494. [Google Scholar] [CrossRef]
- Odonkor, S.T.; Addo, K.K. Bacteria resistance to antibiotics: Recent trends and challenges. Int. J. Biol. Med. Res. 2011, 2, 1204–1210. [Google Scholar]
- Khan, S.; Rukayadi, Y.; Jaafar, A.H.; Ahmad, N.H. Antibacterial potential of silver nanoparticles (SP-AgNPs) synthesized from Syzygium polyanthum (Wight) Walp. against selected foodborne pathogens. Heliyon 2023, 9, e22771. [Google Scholar] [CrossRef]
- Netai, M.M.; Stephen, N.; Musekiwa, C. Synthesis of silver nanoparticles using wild Cucumis anguria: Characterization and antibacterial activity. Afr. J. Biotechnol. 2017, 16, 1911–1921. [Google Scholar]
- Franci, G.; Falanga, A.; Galdiero, S.; Palomba, L.; Rai, M.; Morelli, G.; Galdiero, M. Silver nanoparticles as potential antibacterial agents. Molecules 2015, 20, 8856–8874. [Google Scholar] [CrossRef]
- Contreras, A.; Vazquez, D. Cooperative and antagonistic interactions of peptidyl-tRNA and antibiotics with bacterial ribosomes. Eur. J. Biochem. 1977, 74, 539–547. [Google Scholar] [CrossRef]
- Haseef, H.M.A.; Dinesh, S.; Prakash, J.; Marvaan, M.S.; Madasamy, S.; Pannerselvam, B.; Venkatasubbu, G.D. Calcium oxide/silica nanocomposite and L. coromandelica bark incorporated κ-carrageenan/sodium alginate hy-drogel for rapid hemostasis. Int. J. Biol. Macromol. 2024, 254, 127951. [Google Scholar] [CrossRef] [PubMed]
- Dizaj, S.M.; Lotfipour, F.; Barzegar-Jalali, M.; Zarrintan, M.H.; Adibkia, K. Antimicrobial activity of the metals and metal oxide nanoparticles. Mater. Sci. Eng. C 2014, 44, 278–284. [Google Scholar] [CrossRef] [PubMed]
- Ahmed, S.; Ahmad, M.; Swami, B.L.; Ikram, S. A review on plants extract mediated synthesis of silver nanoparticles for antimicrobial applications: A green expertise. J. Adv. Res. 2016, 7, 17–28. [Google Scholar] [CrossRef] [PubMed]
- Torkaman, M.; Moradi, R.; Keyvani, B. Photocatalytic degradation azo dye Direct Red 23 using carbon nanotubes particles by UV/H2O2 process in batch photoreactor. Rev. Roum. Chim. 2016, 61, 763–772. [Google Scholar]
- Ismail, M.; Akhtar, K.; Khan, M.I.; Kamal, T.; Khan, M.A.; Asiri, A.; Seo, J.; Khan, S.B. Pollution, toxicity and carcinogenicity of organic dyes and their catalytic bio-remediation. Curr. Pharm. Des. 2019, 25, 3645–3663. [Google Scholar] [CrossRef]
- Yogalakshmi, K.N.; Das, A.; Rani, G.; Jaswal, V.; Randhawa, J.S. Nano-bioremediation: A new age technology for the treatment of dyes in textile effluents. In Bioremediation of Industrial Waste for Environmental Safety: Volume I: Industrial Waste and Its Management; Springer: Berlin/Heidelberg, Germany, 2020; pp. 313–347. [Google Scholar]
- Lidia, F.; Maria, H. TiO2/Fly Ash nanocomposite for photodegradation of organic pollutant. In Handbook of Nano-Materials and Nanocomposites for Energy and Environmental Applications; Springer: Cham, Switzerland, 2020; pp. 1–24. [Google Scholar]
- Vanaja, M.; Paulkumar, K.; Baburaja, M.; Rajeshkumar, S.; Gnanajobitha, G.; Malarkodi, C.; Sivakavinesan, M.; Annadurai, G. Degradation of methylene blue using biologically synthesized silver nanoparticles. Bioinorg. Chem. Appl. 2014, 19, 2014. [Google Scholar] [CrossRef]
- Al-Zaban, M.I.; Mahmoud, M.A.; AlHarbi, M.A. Catalytic degradation of methylene blue using silver nanoparticles synthesized by honey. Saudi J. Biol. Sci. 2021, 28, 2007–2013. [Google Scholar] [CrossRef]
- Fairuzi, A.A.; Bonnia, N.N.; Akhir, R.M.; Abrani, M.A.; Akil, H.M. 2018, January. Degradation of methylene blue using silver nanoparticles synthesized from Imperata cylindrica aqueous extract. IOP Conf. Ser. Earth Environ. Sci. 2018, 105, 012018. [Google Scholar] [CrossRef]
- Kumar, M.S.; Supraja, N.; David, E. Photocatalytic degradation of methylene blue using silver nanoparticles synthesized from Gymnema sylvestre and antimicrobial assay. Nov. Res. Sci. 2019, 2, 1–7. [Google Scholar]
- Ogundare, S.A.; Adesetan, T.O.; Muungani, G.; Moodley, V.; Amaku, J.F.; Atewolara-Odule, O.C.; Yussuf, S.T.; Sanyaolu, N.O.; Ibikunle, A.A.; Balogun, M.S.; et al. Catalytic degradation of methylene blue dye and antibacterial activity of biosynthesized silver nanoparticles using Peltophorum pterocarpum (DC.) leaves. Environ. Sci. Adv. 2023, 2, 247–256. [Google Scholar] [CrossRef]
- Trieu, Q.A.; Le, C.T.B.; Pham, C.M.; Bui, T.H. Photocatalytic degradation of methylene blue and antibacterial activity of silver nanoparticles synthesized from Camellia sinensis leaf extract. J. Exp. Nanosci. 2023, 18, 2225759. [Google Scholar] [CrossRef]
- Alam, M.W.; Aamir, M.; Farhan, M.; Albuhulayqah, M.; Ahmad, M.M.; Ravikumar, C.R.; Dileep Kumar, V.G.; Ananda Murthy, H.C. Green synthesis of Ni-Cu-Zn based nanosized metal oxides for photocatalytic and sensor applications. Crystals 2021, 11, 1467. [Google Scholar] [CrossRef]

| S.No. | Phytochemical Class | M. cymbalaria Leaf Extract |
|---|---|---|
| 1 | Alkaloids | ++ |
| 2 | Flavonoids | ++ |
| 3 | Tannins | − |
| 4 | Phenols | + |
| 5 | Steroids | + |
| 6 | Saponin | ++ |
| 7 | Terpenoids | + |
| 8 | Carbohydrates | + |
| 9 | Phlobatannins | − |
| Peak | R. Time | Area | Area% | Name |
|---|---|---|---|---|
| 1 | 6.409 | 4,709,431 | 1.66 | S-Methyl-L-cysteine, N-(ethoxyca… |
| 2 | 6.602 | 3,217,202 | 1.14 | S-Methyl-L-cysteine, N-(ethoxyca… |
| 3 | 8.523 | 2,997,683 | 1.06 | 4H-Pyran-4-one, 2, 3-dihydro-3,5-… |
| 4 | 9.764 | 24,034,843 | 8.49 | 5-Hydroxymethylfurfural |
| 5 | 13.094 | 13,332,417 | 4.71 | 2-Isopropoxyethyl propionate |
| 6 | 13.422 | 10,307,348 | 3.64 | 1,3-Dioxane, 4,4-dimethyl- |
| 7 | 15.066 | 3,657,786 | 1.29 | Humulenol-II |
| 8 | 16.374 | 5,827,800 | 2.06 | Tetradecanoic acid |
| 9 | 17.096 | 2,281,005 | 0.81 | Cyclohexanol, 3-ethenyl-3-methyl… |
| 10 | 17.834 | 3,981,804 | 1.41 | (3S,3aS,6R,7R,9aS)-1, 1, 7-Trimeth… |
| 11 | 18.237 | 2,697,462 | 0.95 | Palmitoleic acid |
| 12 | 18.514 | 59,065,176 | 20.86 | n-Hexadecanoic acid |
| 13 | 20.208 | 111,488,797 | 39.37 | Oleic Acid |
| 14 | 20.393 | 31,876,258 | 11.26 | Octadecanoic acid |
| 15 | 22.800 | 3,678,672 | 1.30 | Dehydroabietic acid |
| S.No | Catalyst | Pollutant | Degradation Efficiency (%) and Time | References |
|---|---|---|---|---|
| 1 | Morinda tinctoria-Ag | MB | 95.3% & 72 h | [104] |
| 2 | Honey-Ag | MB | 92% & 72 h | [105] |
| 3 | Imperata cylindrical-Ag | MB | 92.06% & 14 min | [106] |
| 4 | Gymnema sylvestre-Ag | MB | 95% & 7 h | [107] |
| 5 | Peltophorum pterocarpum-Ag | MB | 82% & 6 min | [108] |
| 6 | Camellia sinensis-Ag | MB | 95% & 72 h | [109] |
| 7 | Momordica cymbalaria-Ag | MB | 60% & 3 h | Present work |
Disclaimer/Publisher’s Note: The statements, opinions and data contained in all publications are solely those of the individual author(s) and contributor(s) and not of MDPI and/or the editor(s). MDPI and/or the editor(s) disclaim responsibility for any injury to people or property resulting from any ideas, methods, instructions or products referred to in the content. |
© 2024 by the authors. Licensee MDPI, Basel, Switzerland. This article is an open access article distributed under the terms and conditions of the Creative Commons Attribution (CC BY) license (https://creativecommons.org/licenses/by/4.0/).
Share and Cite
Sundar, M.; Rajagopal, G.; Nivetha, A.; Prabu Kumar, S.; Muthukumar, S. Phyto-Mediated Green Synthesis of Silver Nanoparticles Using an Aqueous Leaf Extract of Momordica cymbalaria: Antioxidant, Cytotoxic, Antibacterial, and Photocatalytic Properties. Separations 2024, 11, 61. https://doi.org/10.3390/separations11020061
Sundar M, Rajagopal G, Nivetha A, Prabu Kumar S, Muthukumar S. Phyto-Mediated Green Synthesis of Silver Nanoparticles Using an Aqueous Leaf Extract of Momordica cymbalaria: Antioxidant, Cytotoxic, Antibacterial, and Photocatalytic Properties. Separations. 2024; 11(2):61. https://doi.org/10.3390/separations11020061
Chicago/Turabian StyleSundar, Madasamy, Gopalan Rajagopal, Ambikapathi Nivetha, Seetharaman Prabu Kumar, and Selvaraj Muthukumar. 2024. "Phyto-Mediated Green Synthesis of Silver Nanoparticles Using an Aqueous Leaf Extract of Momordica cymbalaria: Antioxidant, Cytotoxic, Antibacterial, and Photocatalytic Properties" Separations 11, no. 2: 61. https://doi.org/10.3390/separations11020061
APA StyleSundar, M., Rajagopal, G., Nivetha, A., Prabu Kumar, S., & Muthukumar, S. (2024). Phyto-Mediated Green Synthesis of Silver Nanoparticles Using an Aqueous Leaf Extract of Momordica cymbalaria: Antioxidant, Cytotoxic, Antibacterial, and Photocatalytic Properties. Separations, 11(2), 61. https://doi.org/10.3390/separations11020061

